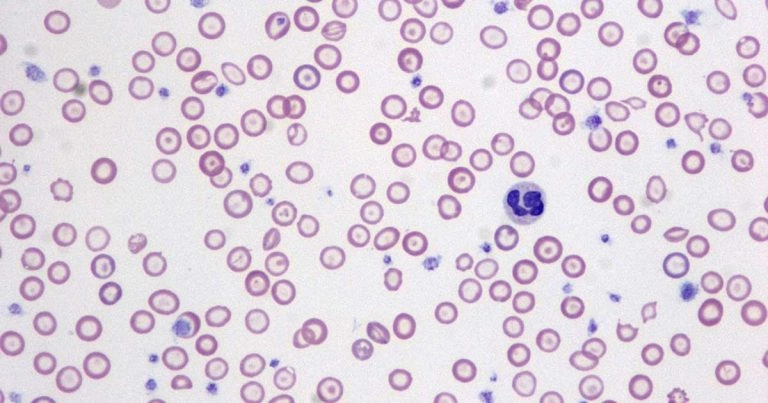

當飼主發現狗狗變得沒精神、活動力下降,甚至牙齦顏色變淡時,往往容易誤以為只是「老了」或「天氣影響」。然而,這些看似普通的症狀,可能是潛藏的嚴重問題,小心狗狗得了貧血(Anemia)。在臨床上,犬隻貧血不僅常見,若未及時診斷與治療,甚至可能危及生命。
本篇將深入解析狗狗貧血的原因、症狀、診斷方式與治療策略,幫助飼主及早辨識關鍵警訊。
什麼是貧血?
貧血是指血液中紅血球(RBC)數量或血紅素(Hemoglobin)濃度下降,導致攜氧能力不足的狀態。紅血球的主要功能是將氧氣從肺部運送到全身各個組織,因此當其數量或功能異常時,身體便無法獲得足夠氧氣。
臨床上常透過以下指標判斷是否有貧血情形:
- 血容比(PCV, Packed Cell Volume)下降
- 血紅素濃度降低
- 紅血球數量減少
當氧氣運輸能力下降,身體組織便會出現缺氧狀態,進而影響各器官功能。隨著貧血程度加重,可能出現精神不佳、活動力下降等臨床症狀,嚴重時甚至會危及生命。
狗狗貧血的常見症狀

初期症狀(容易被忽略)
在貧血初期,症狀通常較不明顯,容易被忽略或誤認為只是短暫疲勞:
- 精神不佳、嗜睡
- 食慾下降
- 活動力減少
- 運動耐受力降低
明顯症狀
隨著貧血程度加重,臨床表現會逐漸變得明顯:
- 牙齦蒼白(正常應為粉紅色)
- 結膜顏色變淡
- 呼吸急促
- 心跳加快
嚴重症狀(需立即就醫)
當貧血進一步惡化,可能出現危及生命的情況:
- 虛弱無力甚至倒地
- 昏厥
- 四肢冰冷
- 黏膜呈現灰白或黃疸
特別提醒:牙齦顏色是最容易觀察的關鍵指標之一,建議飼主平時建立檢查習慣。
狗狗貧血的分類與原因

依照病理機制,犬隻貧血可分為三大類:
失血性貧血(Blood Loss Anemia)
最常見原因之一。
急性失血:
- 外傷(車禍、咬傷)
- 手術後出血
- 內出血(脾臟腫瘤破裂)
急性失血的特點是短時間內大量失血,身體來不及補償,可能迅速導致休克,屬於需要緊急處理的情況。
慢性失血:
- 腸胃道潰瘍
- 寄生蟲(如鉤蟲)
- 泌尿道出血
慢性失血的問題在於進展緩慢,初期症狀不明顯,但紅血球會持續流失,因此容易被忽略,直到貧血變嚴重才被發現。
溶血性貧血(Hemolytic Anemia)
紅血球被過度破壞。
常見原因:
- 免疫介導性溶血性貧血(IMHA)
- 血液寄生蟲(如Babesia)
- 毒素(如洋蔥、中毒藥物)
- 蛇毒
其中 IMHA(免疫介導性溶血性貧血) 是臨床上非常重要且可能致命的急症,因為免疫系統會錯誤攻擊自身紅血球,導致快速惡化。
延伸閱讀:狗狗精神差、牙齦變白?小心 IMHA 自體免疫性溶血
生成不足性貧血(Non-regenerative Anemia)
骨髓無法正常製造紅血球。
可能原因:
- 慢性腎病(EPO不足)
- 骨髓疾病(如再生不良性貧血)
- 腫瘤
- 長期慢性發炎
這類貧血多為慢性發展,臨床症狀可能較為隱性,但因為問題出在紅血球的生成來源,治療上通常較為複雜,需針對潛在疾病進行處理。
更多牙痛獸醫資源
我近期很努力在YT上分享實用的資訊,主要是拍攝貓咪和狗狗醫療資訊! 如果您有興趣,請務必按下訂閱
想要知道更多關於讓毛小孩陪我們更久的資訊嗎?免費贈送養寵必備急救術趕快來領取!
註冊線上研討會:毛孩家長的必修課 (限時免費教學)
透過此課程,至少可以減少10萬的寵物開銷,同時讓你最愛的毛孩,健康快樂的陪伴你更久
預約看診,可至順心動物醫院 07-3809382
如何判斷狗狗是否貧血?

當懷疑狗狗有貧血時,需透過獸醫進行完整檢查,才能確認診斷並找出原因。
獸醫幫狗狗治療與診斷
獸醫師會透過以下檢查進行評估與判斷:
血液學檢查(CBC)
- PCV / HCT(血容比)
- RBC 數量
- Hemoglobin
為最基本且必要的檢查,可初步判斷是否有貧血及其嚴重程度。
網狀紅血球(Reticulocyte count)
用於判斷是否為「再生性貧血」,了解骨髓是否有正常反應:
- 高:骨髓有反應(如失血或溶血)
- 低:可能為骨髓生成問題
血液塗片檢查
透過顯微鏡觀察血液細胞狀態,有助於進一步判斷原因:
- 紅血球形態
- 是否有寄生蟲
- 溶血現象
進一步檢查
依臨床狀況選擇進行,以找出潛在病因:
- X 光 / 超音波(評估內出血或腫瘤)
- 血液寄生蟲 PCR
- 骨髓穿刺
- 生化檢查(如腎功能評估)
狗狗貧血的治療方式

治療原則為:找出原因 + 支持療法,需同時改善臨床症狀並處理根本問題。
輸血治療
適用於:
- 嚴重貧血:PCV < 15–20%
- 伴隨臨床症狀:如虛弱、呼吸急促
- 有生命危險
可在短時間內補充紅血球,快速改善組織缺氧狀態,穩定生命徵象,但屬於支持性治療,無法解決根本病因。
藥物治療
依病因不同選擇適當用藥:
- 免疫抑制劑(如類固醇)→ IMHA
- 抗生素或抗寄生蟲藥
- 止血藥
- 胃腸保護藥(慢性出血)
藥物治療的重點在於控制病因與減少持續性損傷,通常需依照檢查結果調整治療策略。
營養支持
- 高蛋白飲食
- 補充鐵、維生素 B12、葉酸
有助於紅血球生成與整體恢復,但單純補充營養或鐵質通常無法治療多數貧血,仍需搭配其他治療。另外,僅在缺鐵性貧血時,補鐵才具有明確效果。
治療原發疾病
例如:
- 腫瘤切除
- 控制腎病
- 治療感染
這是最關鍵的一步,若未處理根本原因,貧血往往會反覆發生或持續惡化,因此需依診斷結果進行完整治療。
延誤治療的風險
若未及時發現並治療貧血,隨著紅血球持續下降與氧氣運輸能力不足,可能導致嚴重併發症:
- 器官缺氧(特別是心臟、腦部等高耗氧器官)
- 精神狀態快速惡化、虛弱加重
- 多重器官功能受損甚至衰竭
- 低血氧性休克
- 死亡
在部分急性疾病中,如免疫介導性溶血性貧血(IMHA)或急性內出血,病情可能在短時間內快速惡化,甚至在數小時內出現危及生命的變化,因此早期發現與即時治療非常重要。
延伸閱讀:狗狗容易瘀青、流鼻血?可能是血小板低下的症狀與警訊
超高cp質團購群:https://lin.ee/zGmvaie
飼主如何觀察狗狗是否貧血?

日常觀察重點
飼主可以透過日常互動,初步觀察狗狗是否出現疑似貧血的徵兆:
- 牙齦顏色(粉紅 vs 蒼白)
- 精神與活動力是否下降
- 呼吸是否變快或較費力
- 是否容易疲倦、活動後恢復較慢
這些變化通常是早期警訊,建議持續觀察其變化趨勢,而非單一時間點判斷。
定期健康檢查
除了日常觀察外,定期健康檢查也能幫助及早發現潛在問題:
建議頻率:
- 年輕犬:每年 1 次
- 熟齡犬:每 6 個月 1 次
透過血液檢查,可以在症狀出現前就發現早期異常。
高風險族群需特別注意
部分狗狗族群較容易出現貧血,需提高警覺:
- 有慢性疾病(如腎病、腫瘤)
- 曾有免疫相關疾病
- 長期使用藥物
- 戶外活動頻繁、寄生蟲暴露風險較高
這些犬隻建議更密切觀察精神、食慾與牙齦顏色變化,以便及早就醫評估。
更多牙痛獸醫資源
我近期很努力在YT上分享實用的資訊,主要是拍攝貓咪和狗狗醫療資訊! 如果您有興趣,請務必按下訂閱
想要知道更多關於讓毛小孩陪我們更久的資訊嗎?免費贈送養寵必備急救術趕快來領取!
註冊線上研討會:毛孩家長的必修課 (限時免費教學)
透過此課程,至少可以減少10萬的寵物開銷,同時讓你最愛的毛孩,健康快樂的陪伴你更久
預約看診,可至順心動物醫院 07-3809382
狗狗貧血病例

就診對象
一隻3歲、公的羅威納犬。
就診原因
因反覆出現嘔吐、腹瀉、體溫過低與精神不振轉診至本院。症狀約於20天前開始,曾在原就診獸醫處接受抗生素與輸液治療後暫時改善,但數日後再度復發。初步檢查結果無特異性,且當時未檢測電解質。無過度運動或誤食異物病史。
臨床檢查
入院時檢查顯示體溫36.6°C(低體溫)、精神沉鬱、脫水、口腔黏膜蒼白及毛細血管回填時間延長(5秒)。
血液學與生化檢查結果顯示:
- 再生性貧血
- 白血球增多
- 血小板減少
- 輕度高血糖
- 氮血症
- 肝指數升高
- 電解質異常
四天前於當地診所檢測之血容比(HCT)為49.2%,推測本次貧血為急性發生。血液塗片顯示紅血球大小不均(anisocytosis)及巨大血小板(megathrombocytes)。
影像學檢查:
- X光顯示心臟偏小(提示循環血量下降)
- 結腸至直腸有糞便滯留
- 超音波顯示左側腎上腺厚度4.2 mm,右側未能辨識
- 無胸腔或腹腔積液,亦無腫瘤或異物跡象
糞便檢查未發現寄生蟲。
尿液分析:比重1.011、pH 7.1,無蛋白、葡萄糖、酮體或膽紅素,細菌培養陰性。
住院期間血液檢查顯示紅血球、血紅素及血容比持續下降,於第4天後接受輸血治療。
治療方式
初步診斷懷疑為低血容量性休克,可能與腎上腺功能低下(Hypoadrenocorticism, HA)及出血或免疫介導性溶血有關。
治療措施包括:
- 生理食鹽水輸液(8 ml/kg/hr,後調整為5 ml/kg/hr)
- 單次靜脈注射地塞米松(0.1 mg/kg)
- ACTH刺激試驗(使用tetracosactide acetate)確診HA(皮質醇反應低於檢測極限)
- 輸血400 ml(於第4天)
- 出院後給予氟氫可體松(fludrocortisone acetate)治療
後續治療調整:
- 增加氟氫可體松劑量
- 視需要給予prednisolone
- 改為每月注射desoxycorticosterone pivalate(DOCP)
治療結果
住院期間症狀改善,精神與食慾恢復。雖未再出現嘔吐與腹瀉,但觀察到黑便(melena),高度懷疑為腸胃道出血導致急性貧血。
排除免疫介導性溶血性貧血(Coombs test陰性、無自體凝集、無球形紅血球、無黃疸)。低膽紅素亦支持非溶血性原因。
經治療後:
- 腸胃道出血停止
- 紅血球指標逐漸恢復
- 6個月後血容比回升至48.7%(正常範圍)
- Na/K比值改善至36.3,整體狀況穩定
本案例顯示,腎上腺功能低下(HA)可能併發腸胃道出血,進而導致嚴重甚至致命的急性貧血。即使未使用會誘發潰瘍的藥物,仍可能發生出血。因此,當犬隻出現嚴重貧血時,應納入腸胃道出血與內分泌疾病的鑑別診斷,並及早介入治療。
狗狗貧血常見QA
結語
貧血不是小事,觀察牙齦就是救命關鍵。
狗狗不會說話,但身體會透露訊號。當出現「精神不好 + 牙齦蒼白」這組合時,絕不能掉以輕心。
貧血本身不是疾病,而是一個潛在嚴重問題的警訊。及早診斷與治療,不僅能提高存活率,也能大幅改善生活品質。
記住一句話:
「看到蒼白牙齦,就該想到貧血;想到貧血,就要立刻看獸醫。」

